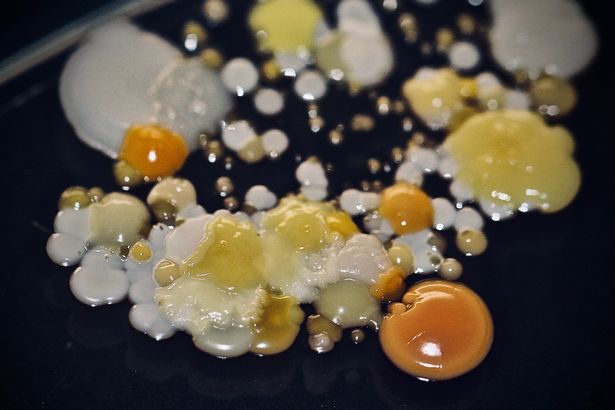

montsepuiggené
@mpuiggene
Metgessa. Especialista Medicina del Treball. Unitat Salut Laboral RS Lleida i RS Alt Pirineu i Aran.
ID: 207249675
24-10-2010 22:04:11
526 Tweet
193 Followers
312 Following


📌 Avui la directora de l'#ICSSL participa en la inauguració de la 7a Jornada Catalana d'#InfermeriaDelTreball i #SalutLaboral, fent èmfasi en el paper important i rellevant que juga en l'equip multidisciplinar de la modalitat organitzativa de l'empresa. ACITSL Col·legi d'Infermeres i Infermers de BCN (COIB)






XXXIIIDiada SALUT LABORAL Un pas endavant organizada Salut Laboral Inauguració amb Carmen Cabezas Salut #USLleidaAltPA #salutlaboralcat #diada cita anual de la medicina del treball, infermeria, técnics de #PRL i tots els que treballem en salut laboral


XXXIIIDiada SALUT LABORAL Un pas endavant organizada Salut Laboral Rafael Panades #salutlaboralcat presenta al Dr. Antoni Trilla Antoni Trilla Situació actual. Long COVID. One Health. Un privilegi que comparteixis amb nosaltres coneixements i reflexions. Gràcies Sebastiana Quesada Fuentes


XXXIIIDiada SALUT LABORAL Un pas endavant organizada Salut Laboral. El Dr. Pere Godoy Pere Godoy presenta Registres de càncer a Catalunya. I de càncer laboral? Perspectives de futur. Per poder actuar en prevenció del càncer laboral Salut #USLleidaAltPA #salutlaboralcat #diada








#JornadadeDoctorat Jaume Puy @AngelsBalsellsBailon Jornada de Doctorat 2023 de l’Escola de Doctorat de l’Universitat de Lleida. Formaos, la sociedad os necesita por Belén Villacampa Campus Iberus International Campus Iberus #USLleida #USLAltPA #salutlaboralCAT




I Congrés Medicina i Salut Ambiental #societat catalana de salut ambiental Col·legi Metges BCN Carmen Cabezas Salut Entorn saludable és molt important per a la salut